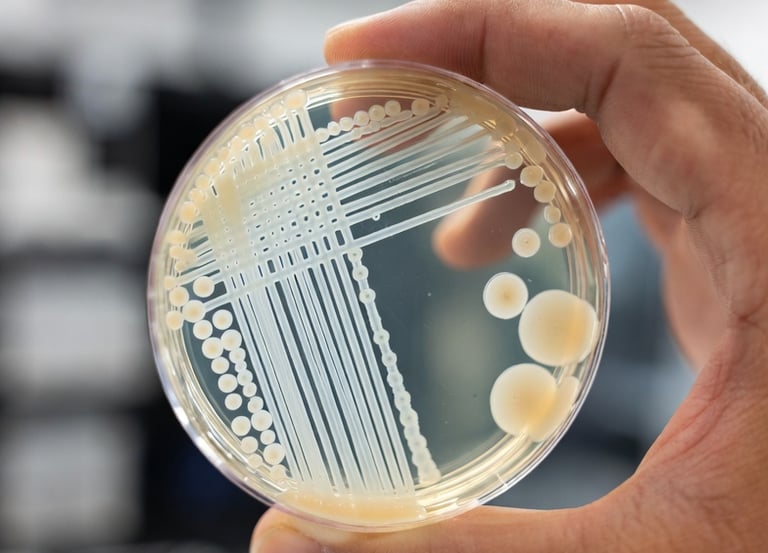
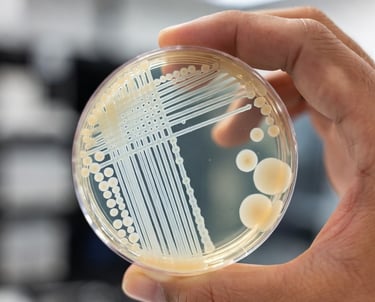

specialty Coating IP Technologies for Aerospace, healtcare, Marine & Defense

About us
DIAMIX® - Diamond-backed specialty coatings
A.C.E. B.V. develops a portfolio of specialty coating IPs under the DIAMIX® brand.
Utilising the unique properties of synthetically modified diamond products, we create specialty coatings for Multi-industry applicability that span ESD mitigation, antibacterial, antifouling and smart coating solutions. The coatings are covered by a published patent and a Patent Cooperation Treaty (PCT) application filed covering up to 158 jurisdictions. All products have been independently tested by accredited laboratories or computationally verified.
Our coatings offer extreme durability, corrosion resistance, are biocompatible, lightweight and scalable.
They address problems in aerospace, healthcare, marine and defence industries with a combined Total Addressable Market (TAM) of 82.52B USD.
High-performance coatings powered by synthetic diamond innovations. Independently tested, patent-protected, and ready for licensing or technology transfer!
Accelerating Innovation and Protecting Your Market
Strong intellectual property is a strategic asset. Acquiring additional patents protects your market position, builds essential freedom-to-operate, and shields the trade secrets that set your technologies apart. It also accelerates R&D, enabling faster product launches and premium differentiation across new or existing product lines.
A robust patent portfolio opens doors commercially—expanding addressable markets, strengthening negotiation leverage, and creating long-term licensing opportunities. It also enhances company valuation by demonstrating innovation leadership and long-term defensibility.
For organizations aiming to lead in high-performance surface technologies, the right patents are not just protection—they are a catalyst for growth.
We’re offering a high-value patent with multiple independently validated use cases, protected in over 150 jurisdictions with Freedom to Operate. If your team is exploring next-generation coating technologies or aiming to strengthen your innovation pipeline, we invite you to reach out for technical documentation and a deeper discussion.


Our Product Lines
A Portfolio Designed for Mission-Critical Performance
DIAMIX®-static
Developed to address ESD mitigation in the aerospace and semi-conductor industry.


A specialty coating for ESD mitigation and heat dissipation, 2.5x lighter than copper, reducing weight, fuel use and CO2 emissions while improving adhesion and reducing maintenance in aerospace. Up to 95% below the highest permissible ESD value in aerospace standards and unaffected by 15kV discharges, outperforming any other ESD mitigating coatings currently on the market.
DIAMIX®-static addresses challenges in the Aerospace Industry where heavy copper mesh for Electrostatic Discharge (ESD) mitigation increases weight and fuel costs, adhesion issues, and maintenance costs. (TAM 2030: 35.72B USD). With additional use cases in the semiconductor and other specialty industries.
Independently tested and verified by Eurofins Maser.
RTCA-DO160 standard
DIAMIX®-shield
A game-changer in the Healthcare industry.

A bio-compatible specialty coating, delivering both antibacterial protection of up to 400% better performance than copper-based coatings and extreme durability for healthcare and industrial applications.
Exceeding log reductions of TiO2, Cu- and Ag-based coatings while eliminating chemical reliance.
DIAMIX®-shield addresses challenges in the Healthcare Industry where surfaces lack durable, self-sustaining antibacterial protection and are relying on aggressive chemical disinfectants. (TAM 20230: 24.65B USD)
Independently tested and verified by CHILL labs.
ISO 22196:2011 Measurement of antibacterial activity on plastics and other non-porous surfaces.
DIAMIX®-guard
Eco-friendly anti-fouling for the Marine industry.


A true eco-friendly antifouling coating prevents marine biofouling with biocide-free protection as an alternative to harmful copper and zinc-based coatings.
Offering superior inert eco-friendliness, versatile performance, regulatory alignment and unmatched durability, positioning it as a premium, future-proof solution in the biocide-free antifouling market.
DIAMIX®-guard addresses challenges in the Marine Industry where biofouling drives up fuel consumption, maintenance costs, and environmental harm, while strict regulations against copper and zinc in traditional antifouling coatings demand eco-friendly alternatives. (TAM 2030: 2.65B USD)
Independently tested and verified by CHILL labs.*
ISO 21716 (Ships and marine technology -Bioassay methods for screening anti-fouling paints, Section 4)
*in progress
DIAMIX®-sense
Quantum sensing infrastructure, deployed at the surface.
DiamiX-Sense integrates nitrogen-vacancy (NV) centers into a diamond-infused polymer matrix, deployable as a surface coating on any structure. No embedded electronics. No wiring. No downtime. The coating becomes the sensor — delivering continuous, real-time structural intelligence at nanoscale precision: temperature to 0.001 K, mechanical stress to 1 nanoTesla, and electromagnetic field detection for active stealth applications.
Critical infrastructure in aerospace, defense, and high-tech manufacturing operates blind. Traditional inspection regimes are periodic, expensive, and reactive — the data gap between last inspection and next failure costs billions annually, and in defense, it costs lives. DiamiX-Sense replaces this paradigm entirely: where conventional approaches add sensing hardware to a structure, DiamiX-Sense makes the structure itself the sensor. Dual-use across military and civilian platforms, with a combined Total Addressable Market exceeding $21.75B by 2030.
Technology validated through COMSOL Multiphysics simulation and IBM's Qiskit quantum development framework
Get in touch
Interested in our IP? Reach out, and we'll tell you more!
Contact
Questions? Reach out anytime, we're here.
© 2025. All rights reserved.
DiamiX® is a registered trademark. Benelux depot no. 1523914
DiamiX-Static™, DiamiX-Shield™, DiamiX-Guard™, and DiamiX-Sense™ are all trademarks of A.C.E. B.V.
A.C.E. B.V. Registered in the Netherlands. Company nr 84027525
VAT NL863067918B01
Disclaimer: All technical information is provided for general purposes only. Performance results vary by application and may require an NDA for full documentation. No warranties are expressed or implied.



